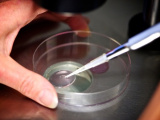

-
 Bóc gỡ đường dây buôn lậu kim cương "khủng" 280 tỷ đồng: Giám đốc giám định PNJ-LAP sa lưới
Bóc gỡ đường dây buôn lậu kim cương "khủng" 280 tỷ đồng: Giám đốc giám định PNJ-LAP sa lưới -
 Nữ thủ khoa đạt điểm tuyệt đối 30/30 khối B00: Hoàn thành chương trình sớm, dành nửa năm chỉ để luyện đề
Nữ thủ khoa đạt điểm tuyệt đối 30/30 khối B00: Hoàn thành chương trình sớm, dành nửa năm chỉ để luyện đề -
 Vợ NSND Công Lý trải lòng sau doanh số 761,5 triệu đồng: "Áp lực tài chính chính là động lực"
Vợ NSND Công Lý trải lòng sau doanh số 761,5 triệu đồng: "Áp lực tài chính chính là động lực" -
 Giá xăng dầu đồng loạt giảm từ 16h hôm nay, E10 RON 95 còn 20.410 đồng/lít
Giá xăng dầu đồng loạt giảm từ 16h hôm nay, E10 RON 95 còn 20.410 đồng/lít -
 Diện mạo thay đổi và lời nhắn nhủ gây xúc động của Ngân 98 sau hơn 8 tháng bị tạm giam
Diện mạo thay đổi và lời nhắn nhủ gây xúc động của Ngân 98 sau hơn 8 tháng bị tạm giam -
 Tháng 7 bùng nổ với 4 bộ phim Hàn Quốc đáng chờ đợi, quy tụ dàn sao đình đám
Tháng 7 bùng nổ với 4 bộ phim Hàn Quốc đáng chờ đợi, quy tụ dàn sao đình đám -
 Nữ thủ khoa tổ hợp A01: Đạt điểm SAT cao nhất thế giới, trúng tuyển ĐH top Hàn Quốc và mê chơi game
Nữ thủ khoa tổ hợp A01: Đạt điểm SAT cao nhất thế giới, trúng tuyển ĐH top Hàn Quốc và mê chơi game -
 Thân thế thủ khoa toàn quốc khối A00, bật mí bí quyết đạt 3 điểm 10 và ngôi trường định đăng ký
Thân thế thủ khoa toàn quốc khối A00, bật mí bí quyết đạt 3 điểm 10 và ngôi trường định đăng ký -
 Nguyên điều tra viên hình sự cao cấp: Vụ phát hiện bộ xương nam MC ở TP HCM là một vụ "án mờ"
Nguyên điều tra viên hình sự cao cấp: Vụ phát hiện bộ xương nam MC ở TP HCM là một vụ "án mờ" -
 Nghi vấn rạn nứt giữa Hoa hậu Thanh Thủy và Trịnh Thăng Bình sau dòng trạng thái lạ
Nghi vấn rạn nứt giữa Hoa hậu Thanh Thủy và Trịnh Thăng Bình sau dòng trạng thái lạ
Thế giới
26/02/2026 15:02Hy hữu vụ con trai 10 tuổi kiện bố ra tòa để đòi lại 11.500 USD tiền lì xì

Sự việc bắt đầu từ Xiaohui, một cậu bé 10 tuổi sống tại Trịnh Châu, tỉnh Hà Nam. Sau khi cha mẹ ly hôn cách đây hai năm, Xiaohui sống cùng bố. Trong suốt nhiều năm, cậu bé đã tích lũy được một khoản "tài sản" đáng kể lên tới hơn 80.000 nhân dân tệ (khoảng 11.500 USD) từ tiền lì xì mỗi dịp Tết. Toàn bộ số tiền này ban đầu được gửi vào một tài khoản ngân hàng riêng do người cha đứng tên mở cho em.
Tuy nhiên, sóng gió bắt đầu nổi lên khi người cha tái hôn và Xiaohui chuyển sang sống với mẹ. Tại đây, mẹ của em tình cờ phát hiện ra toàn bộ số tiền 82.750 nhân dân tệ, bao gồm cả tiền gốc lẫn lãi, đã bị người cha rút sạch mà không hề có sự đồng ý của Xiaohui. Mục đích của hành động này được xác định là để thanh toán các chi phí cho hôn lễ mới của ông.
Đứng trước yêu cầu hoàn trả tiền từ con trai, người cha đã thẳng thừng từ chối với lý lẽ rằng số tiền này đến từ các mối quan hệ xã hội của cá nhân ông, nên ông chỉ có trách nhiệm giao lại khi cậu bé đã trưởng thành. Thậm chí, ông còn cho rằng vụ kiện này thực chất là do người vợ cũ xúi giục con trai nhằm gây khó dễ cho mình.
Tại phiên tòa, công lý đã đứng về phía cậu bé 10 tuổi. Tòa án xác định rằng theo quy định của pháp luật, tiền lì xì là tài sản cá nhân của trẻ em. Dù với tư cách là người giám hộ hợp pháp, cha mẹ có quyền quản lý tài sản vì lợi ích tốt nhất của con, nhưng họ tuyệt đối không được phép tịch thu hay sử dụng số tiền đó cho mục đích cá nhân. Việc người cha tự ý rút tiền để cưới vợ mới đã xâm phạm nghiêm trọng đến quyền tài sản của trẻ vị thành niên. Cuối cùng, tòa án ra phán quyết buộc người cha phải trả lại không thiếu một xu trong tổng số 82.750 nhân dân tệ cho con trai.
Theo Bộ luật Dân sự của Trung Quốc, "tiền may mắn" được xem là một dạng quà tặng thuộc quyền sở hữu của trẻ. Trong khi trẻ dưới 8 tuổi chưa được tự ý sử dụng, thì trẻ trên 8 tuổi như Xiaohui đã có quyền chi tiêu cho các nhu cầu phù hợp với lứa tuổi. Cha mẹ chỉ đóng vai trò là "người giữ hộ" chứ không phải là chủ sở hữu.
Vụ việc ngay lập tức trở thành tâm điểm chỉ trích trên mạng xã hội Trung Quốc. Nhiều cư dân mạng đã không giấu nổi sự mỉa mai dành cho người cha. Một bình luận nhận được nhiều sự đồng tình viết: "Túng quẫn đến mức lấy tiền tiết kiệm của con trai đi cưới vợ mới, đúng là thiên tài!". Người khác lại đặt câu hỏi về trách nhiệm của người đàn ông này: "Nếu nghèo đến mức đó thì tái hôn làm gì? Sao vẫn có người chấp nhận lấy một người như thế?".








- Bóc gỡ đường dây buôn lậu kim cương "khủng" 280 tỷ đồng: Giám đốc giám định PNJ-LAP sa lưới (20:40)
- Triệu phú tiền số bị nhóm con nợ lập mưu sát hại, giấu xác trong vali (20:01)
- Triệt phá đường dây trục lợi nhà ở xã hội: Lật tẩy chiêu trò "suất ngoại giao" để lừa đảo hơn 40 tỷ đồng (1 giờ trước)
- Vụ án tại Tổng công ty Truyền tải điện Quốc gia: Khởi tố 17 người, phong tỏa gần 1.800 tỷ đồng (2 giờ trước)
- Vũ điệu cuối cùng của Ronaldo và Modric khiến giá vé World Cup 2026 chạm ngưỡng kỷ lục 21.000 USD (2 giờ trước)
- Thực hư clip người phụ nữ khách sạn ở biển Hải Tiến ăn vạ tài xế sau khi tranh cãi về Wi-Fi (2 giờ trước)
- Thông tin mới vụ thầy giáo ở Hà Tĩnh bị tố ngoại tình, có con riêng và bạo hành vợ: Sở Giáo dục nói gì? (3 giờ trước)
- Nghệ An: Khẩn trương tìm kiếm nam dân quân để lại tư trang trên cầu rồi mất liên lạc (3 giờ trước)
- Phi công lao máy bay vào tòa nhà cao nhất Bắc Kinh từng muốn tự tử (3 giờ trước)
- Bão số 1 giật cấp 11 hướng vào Vịnh Bắc Bộ, cảnh báo mưa lớn diện rộng từ ngày 3/7 (3 giờ trước)
Bài đọc nhiều